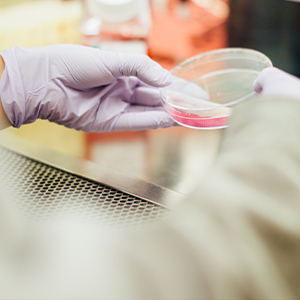

Industries
In many business applications, success requires unlocking the power of the intrinsic information contained in available data both by understanding it deeply and by communicating about it effectively. Whether the issues are time to market, calculating risk, analyzing product features or understanding customer preferences, predictive analytics is a critical tool in the success of data-driven industries.